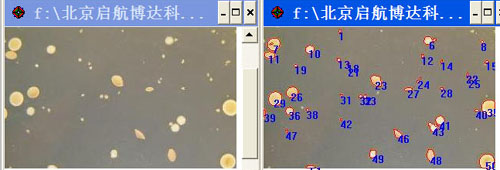

BD-800A全自动影像分析菌落计数仪广泛应用于食品和饮料的品质和卫生检验、水质分析、乳及乳制品的检测、医院临床检验、化妆品检验和药品的品质和质量检测等等,适用于对微生物的菌落计数和计算等,能够完成所有的菌落读数类型,自动读取平板、螺旋、涂布、倾倒等的菌落总数,是现代微生物检测实验室先进和高效的菌落计数器。
一、技术参数
1.培养皿直径:≤150mm;
2.检测方式:全自动;光照方式:顶部&底部透射光
3.典型计数时间:3~6秒(螺旋接种培养皿);摄像镜头:彩色1000万像素
4.计数量:每小时大于400个平板
5.稀释系列:用户自定义模式;数据接口:ieee 1394
6.检测限:1~255mm,±0.1mm;电源:220V/50Hz
7.菌落分辨率:0.1mm,抑菌圈测定:0.05mm;
8.区域选择统计:显示高清晰彩色平皿图像并配有计数工具和选项。众多参数可供设定,使计数效果达到并提高准确性;
9.颜色识别统计:根据颜色特性筛选,分别计数分析特定颜色的菌落数量。
10.菌落粘连分割:自动分割相互粘连的菌落,可由用户选择分割或不分割,能自动分割粘连长形目标。
11.配美国产专业菌落分析软件 可对平皿图像和计数结果进行保存、打印、输出,符合GLP(良好实验室规范)标准,同时该系统完全符合21 CFR Part 11(关于电子记录的世界通行标准)以及US-FDA标准
11、采用全封闭、宽光带照明技术,符合人体工学的舷窗门设计,隔绝环境光的干扰,彻底消除杂散光在玻璃培养皿折射形成的光斑、光环现象,为精确菌落计数提供了必备的光影条件。
常见平皿的菌落计数
蚀斑/噬菌斑计数 
由于平板上噬菌斑与背景反差小,且往往出现多个噬菌斑相连的现象,一般统计设备无法准确识别,目前仍采用人工计数的方式。博达BD-800A可实现扣除背景,粘连噬菌斑的准确分割和精确计数。
放线菌计数

表面纹理复杂是放线菌的特征,主要表现为皱褶多、边缘毛糙、菌丝疏松或致密、中间与边缘色泽不同等。针对这类菌落,博达BD-800A采用Trace contour轮廓跟踪法和随机多边图形检测法对单水平集区域进行分裂操作,获得了很好的菌落计数效果。
霉菌和酵母计数

“霉菌和酵母计数”食品国家标准要求:在孟加拉红培养基或马铃薯-葡萄糖-琼脂培养基28℃培养后,分别计数霉菌和酵母,博达BD-800A集多模型搜索算法”,可实现一键统计一类菌。
大肠菌群计数

按照大肠菌群计数国家标准,结晶紫中性红胆盐琼脂被用于大肠菌群平板计数,菌落呈紫红色,菌落周围有红色的胆盐沉淀环。博达BD-800A可一键完成大肠菌群计数。
大肠埃希氏菌计数
根据大肠埃希氏菌计数的国家标准,即暗室中360 nm~366 nm 波长6W紫外灯照射下,计数平板上发浅蓝色荧光的菌落。BD-800A可设有366nm紫外灯,可激发大肠埃希氏菌荧光,便于观察和计数。
金黄色葡萄球菌检验
博达BD-800A针对Baird-Parker平板上的金黄色葡萄球菌检验问题,利用优化统计算法,排除透明圈的干扰,实现菌落准确计数。
乳酸菌检验
国家标准中乳酸菌主要为乳杆菌属、双歧杆菌属和链球菌属。博达BD-800A同样能够实现在MRS琼脂平板上乳酸菌总数的精确计数。
网格滤膜与3M测试片
在3M测试片或滤膜上进行菌落统计时,传统图像处理方法分割出来的是网格而不是菌落。博达BD-800A推出的“基于形态轮廓模型”分割算法,可实现网格背景下的一键菌落计数
防霉检测 霉菌一键式测量

国家标准规定了塑料防霉性能试验方法,而霉菌面积一般是通过肉眼观察和游标卡尺测量进行估算的。为了精确测定塑料制品的防霉性能,博达BD-800A提供了一项快速防霉检测,通过自动提取霉菌和样品轮廓,由于多数霉菌菌落蔓延、疏松、边缘发散不规则,测量的人为误差大,效率低。 “霉菌一键测量”模块,只需在菌落边缘点击一次,大霉菌的面积、周长、长径、短径瞬间测出。即可准确地计算出相关数值。
基因工程重组子筛选-蓝白斑计数
蓝白斑筛选是根据载体的遗传特征筛选重组子。由α-互补而产生的LacZ+细菌在诱导剂IPTG的作用下,在生色底物X-Gal存在时产生蓝色菌落,当外源DNA插入到质粒的多克隆位点后,几乎不可避免地导致无α-互补能力的氨基端片段,使得带有重组质粒的细菌形成白色菌落
抑菌圈测量
杂质剔除统计
微生物菌落计数过程中常存在杂质问题:如未经过滤的食品样本直接注入培养皿,培养基中存在不溶物、气泡、琼脂凝块等。利用菌落与杂质在形态学上的差异,如大小、颜色、轮廓等,设置一定条件,可滤除特定的杂质。
螺旋平皿
参照美国FDA螺旋计数法则设计,符合出入境检验检疫行业标准-《食品和化妆品中的细菌计数检验法-螺旋平板法》,并支持多个品牌螺旋接种仪的接种模式要求,如美国SBI、西班牙IUL等。
数据管理
系统采用开放式实验报告打印方式,即可将统计信息导出至EXCEL中,并根据行业需要,编辑报告格式。





